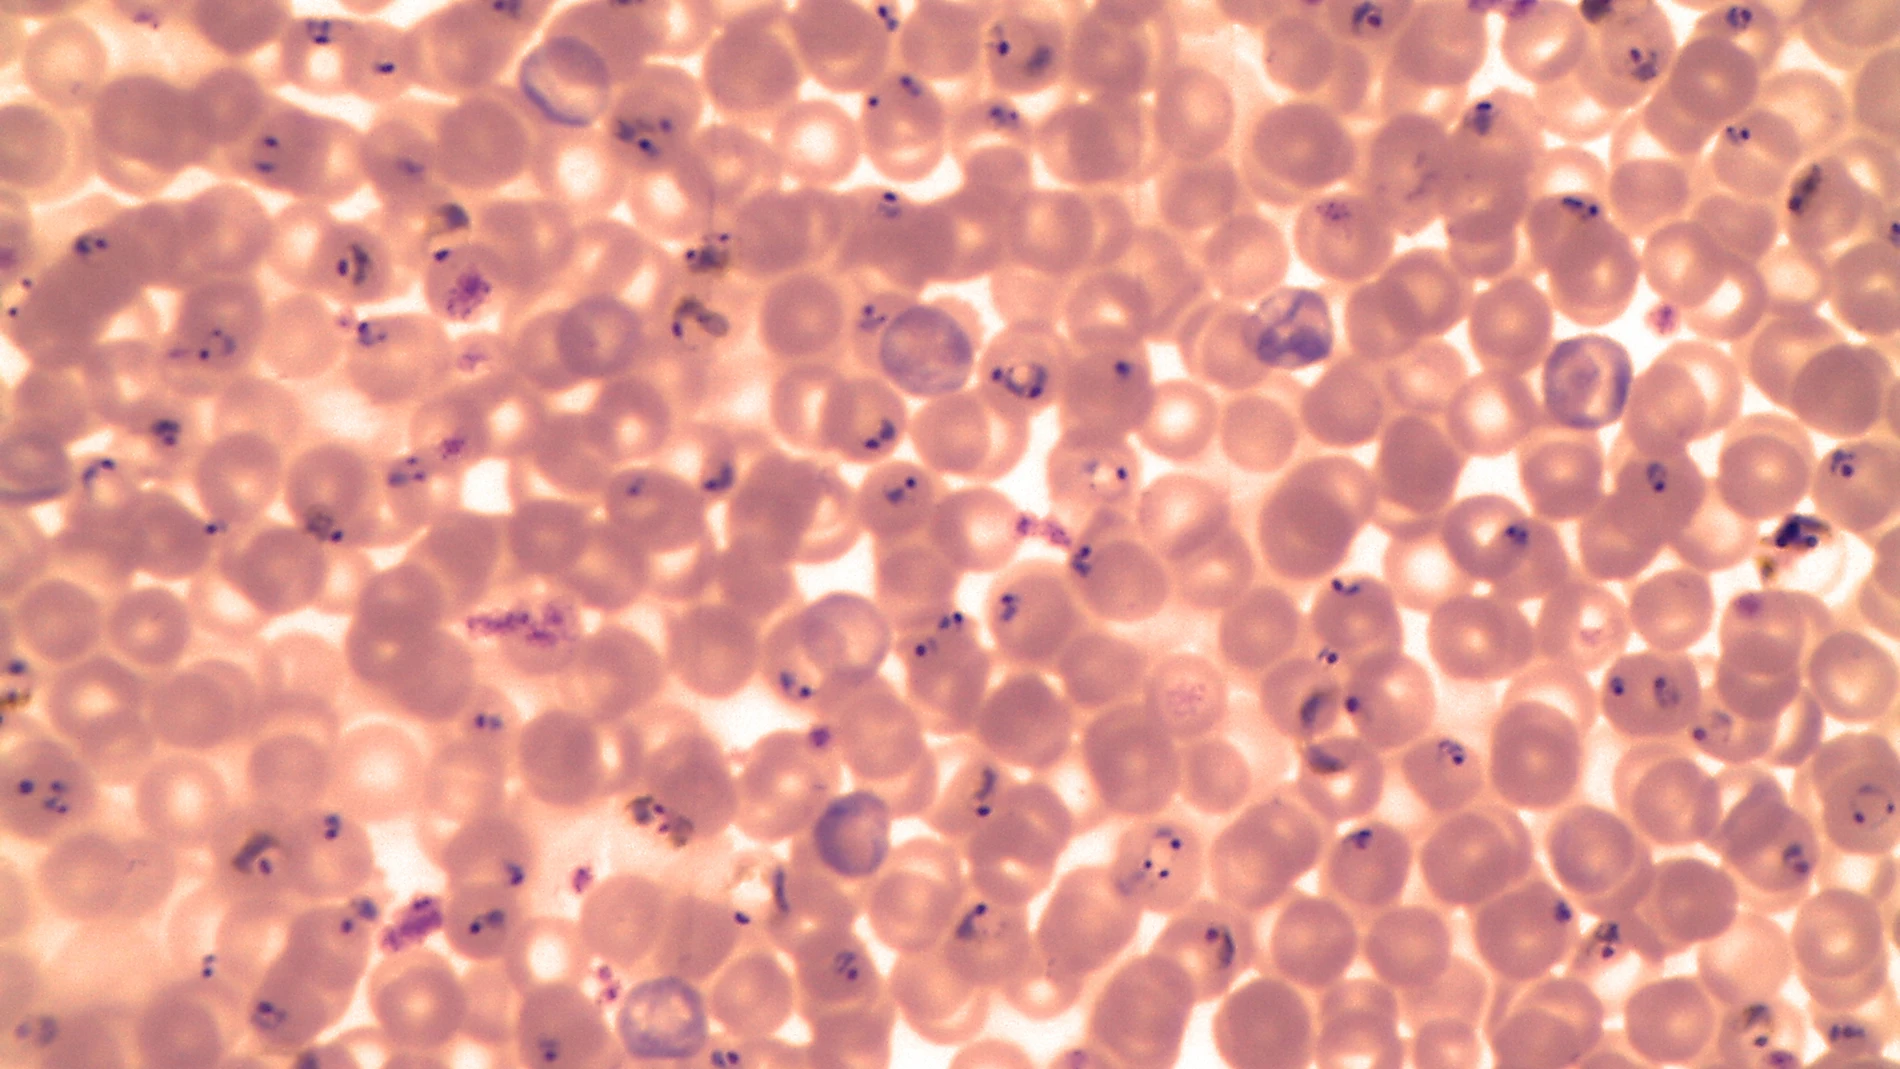
Microfotografía de una muestra de sangre que revela la presencia de numerosos parásitos en forma de anillo de Plasmodium falciparum.

Enfermedades emergentes
La malaria del siglo XXI la provoca un “supermosquito” de ciudad
Es capaz de transmitir conjuntamente los dos parásitos principales que provocan la enfermedad, y amenaza con extenderla a las grandes urbes africanas y europeas
En medio de la nueva ola de preocupación por el aumento de casos de covid procedentes de China, un viejo conocido de las autoridades sanitarias globales vuelve a dar la cara: la malaria. No es una enfermedad del pasado, no es una enfermedad controlada, no es una emergencia banal… a pesar de que en este lado rico del planea nos parece un mal lejano y poco preocupante. La malaria mató en 2021 a 700.000 personas y contagió a cerca de 240 millones, según datos de la Organización Mundial de la Salud (OMS). El 80% de los fallecidos eran niños menores de cinco años. El 95% vivía en África.
Ahora, recientes informes epidemiológicos sugieren que un nuevo vector de la enfermedad puede dificultar aún más los esfuerzos para combatirla. En concreto, se trata de lo que algunos han llamado un “súpermosquito”, Anopheles stephensi, identificado por primera vez en la capital de Sudán, Jartún hace una década y que es capaz de transmitir conjuntamente los dos parásitos principales que provocan la patología: el Plasmodium falciparum y el Plasmodium vivax. El primero es el agente más mortífero y es prevalente en África. El segundo era, hasta ahora, más común fuera del continente africano. Con la proliferación del nuevo vector se teme que la enfermedad se expanda de manera más rápida de lo habitual.
Se ha adaptado a la ciudad
La genetista Udani Smarasekera, editora de The Lancet, acaba de publicar un artículo en la prestigiosa revista sanitaria, en el que se alerta del peligro que supondría perder de vista a esta nueva variedad de vector infeccioso. Según revela, el Anopheles stephensi se ha adaptado en los últimos años a los entornos urbanos, ha aprendido a alimentarse y procrear en los contenedores de agua que proliferan en las regiones densamente pobladas (macetas, jardines, bocas de riego, neumáticos abandonados, charcos…) y ha mejorado sus opciones de supervivencia ante el impacto de insecticidas. “Eso le convierte -afirma la experta- en una herramienta mejorada para la transmisión de la enfermedad con mayores ratios de morbilidad y mortalidad”.
Otro de los autores del artículo de The Lancet, Richard Allan, experto en Salud Global, ha asegurado que “la agresividad contagiosa de este nuevo mosquito es sorprendente. Hemos detectado que allá donde se produce un rápido aumento de la población, por ejemplo por la urbanización de una nueva zona de una ciudad, el vector aparece enseguida”. En los países africanos donde más impacto está teniendo la nueva variante (Nigeria y Sudán sobre todo) suelen producirse obras de urbanización precarias y veloces, con tratamientos inadecuados de las aguas residuales, aumento de los desechos y de las acumulaciones de agua estancada que son el terreno ideal para la aparición de Stephensi.
En otras palabras, nos encontramos con un mosquito que porta dos variedades juntas del patógeno, que crece de manera exponencial y que está perfectamente adaptado a las áreas urbanas donde más población objetivo existe. Las variedades de Anopheles comunes, son más propias de entornos rurales y menos poblados.
De momento no está claro que este mosquito sea también más resistente a los insecticidas, pero algunos informes paracen también apuntar esa posibilidad. En noviembre, la Sociedad Americana de Medicina Tropical emitió un comunicado tras estudiar un brote inusual de malaria en la localidad etíope de Dire Dawa. Esta ciudad no suele sufrir episodios graves de malaria pero los casos se han multiplicado por diez en 2022. El agente causante es, precisamente, A. Stephensi.
De hecho, en los criaderos de mosquitos cercanos a la localidad (zonas agrícolas, restos de aguas estancadas, etc…) el 97% de los insectos recolectados pertenecían a esa especie. Anteriormente, estudios realizados en Camboya y Vietnam habían demostrado que el 78% de los mosquitos de este tipo recolectados en Asia son resistentes a los piretroides ya que portan una mutación en el gen L982W que les confiere hasta 100 veces más capacidad de supervivencia en contacto con este insecticida. En algunos casos es necesario aumentar 1.000 veces la cantidad de agente químico para matar al animal.
Resistente al cambio climático
Otro dato preocupante es que esta nueva variedad parece mejor adaptada aún al calor y la sequía que sus primos cercanos. Es decir, podría encontrar un mejor caldo de cultivo en un entorno de cambio climático global. De hecho, el brote de Dire Dawa es una muestra del inusual comportamiento de este llamado “mosquito urbano”. En esa región de Etiopía, lo más común es que se aprecie algún caso de malaria en las estaciones más húmedas. Pero un aumento en periodo seco es realmente extraño.
El nuevo agente infeccioso africano no es un mosquito desconocido. La ciencia lleva décadas estudiándolo. Pero no se había expandido tanto fuera de Asia como ahora. En Djibouti por ejemplo, no había hecho acto de presencia hasta 2012. Desde entonces, los casos de malaria se han multiplicado por 36.
El comportamiento de este animal se asemeja al de otros mosquitos como los de la especie Aedes (conocidos transmisores de enfermedades como la fiebre del Nilo) que ya han mostrado su capacidad de colonizar regiones más al norte y llegara Europa.
Uno de los mayores conocedores de este nuevo peligro, el doctor Fitsum Grima Tadesse, del Instituto de Investigación Armaeur Hansen de Adis Abeba ha recalcado que Stephensi se está beneficiando de una característica propia de las zonas urbanas: los habitantes están menos protegidos inmunitariamente contra enfermedades más comunes en áreas rurales. La nueva malaria del siglo XXI puede dar el salto a ciudades cada vez más septentrionales y desarrolladas. Pensar que pueda cruzar la frontera con Europa o Estados Unidos no sería descabellado.
✕
Accede a tu cuenta para comentar

Cerco judicial al PSOE




